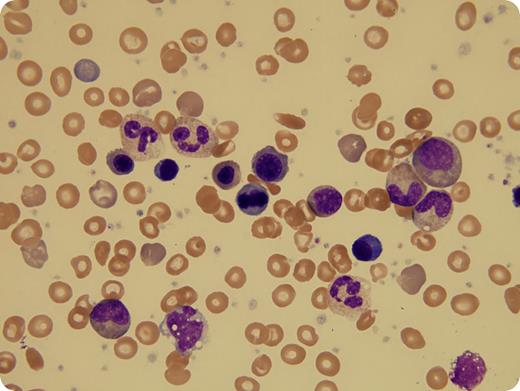
A 3-year-old boy with sickle cell disease (SCD) presented to the emergency room postsplenectomy for abdominal pain and constipation. Upon examination, he was noted to be tachycardic with a 3/6 systolic ejection murmur. Complete blood count showed a white blood cell (WBC) count of 62.3 × 109/L, hemoglobin 50 g/L, platelets 586 × 109/L, mean corpuscular volume 84.3 fL, and 111 nucleated red blood cells (RBCs) per 100 WBCs. Morphologic examination of the peripheral blood showed a leukoerythroblastic smear, including rare blasts and erythroid mitotic figures, and thrombocytosis, including occasional large platelets. Lactate dehydrogenase was 981 U/L and uric acid was 4.7 mg/dL. Given these findings, there was concern for a myeloproliferative neoplasm (MPN), although MPNs are not known to be associated with SCD. However, within 24 hours, his WBC count decreased to 30.7 × 109/L, and his parvovirus polymerase chain reaction was reported as positive. Following transfusion with 10 mL/kg packed RBCs, his tachycardia and abdominal pain resolved, and no further interventions were employed. Within 1 week, his WBC count had normalized to 9.4 × 109/L. / Leukoerythroblastosis that mimics juvenile myelomonocytic leukemia has been reported in neonates with Epstein-Barr virus and cytomegalovirus infections. However, this case of extreme leukocytosis represents an unusual and rarely reported presentation of parvovirus infection in a splenectomized toddler.

A 3-year-old boy with sickle cell disease (SCD) presented to the emergency room postsplenectomy for abdominal pain and constipation. Upon examination, he was noted to be tachycardic with a 3/6 systolic ejection murmur. Complete blood count showed a white blood cell (WBC) count of 62.3 × 109/L, hemoglobin 50 g/L, platelets 586 × 109/L, mean corpuscular volume 84.3 fL, and 111 nucleated red blood cells (RBCs) per 100 WBCs. Morphologic examination of the peripheral blood showed a leukoerythroblastic smear, including rare blasts and erythroid mitotic figures, and thrombocytosis, including occasional large platelets. Lactate dehydrogenase was 981 U/L and uric acid was 4.7 mg/dL. Given these findings, there was concern for a myeloproliferative neoplasm (MPN), although MPNs are not known to be associated with SCD. However, within 24 hours, his WBC count decreased to 30.7 × 109/L, and his parvovirus polymerase chain reaction was reported as positive. Following transfusion with 10 mL/kg packed RBCs, his tachycardia and abdominal pain resolved, and no further interventions were employed. Within 1 week, his WBC count had normalized to 9.4 × 109/L.
Leukoerythroblastosis that mimics juvenile myelomonocytic leukemia has been reported in neonates with Epstein-Barr virus and cytomegalovirus infections. However, this case of extreme leukocytosis represents an unusual and rarely reported presentation of parvovirus infection in a splenectomized toddler.
A 3-year-old boy with sickle cell disease (SCD) presented to the emergency room postsplenectomy for abdominal pain and constipation. Upon examination, he was noted to be tachycardic with a 3/6 systolic ejection murmur. Complete blood count showed a white blood cell (WBC) count of 62.3 × 109/L, hemoglobin 50 g/L, platelets 586 × 109/L, mean corpuscular volume 84.3 fL, and 111 nucleated red blood cells (RBCs) per 100 WBCs. Morphologic examination of the peripheral blood showed a leukoerythroblastic smear, including rare blasts and erythroid mitotic figures, and thrombocytosis, including occasional large platelets. Lactate dehydrogenase was 981 U/L and uric acid was 4.7 mg/dL. Given these findings, there was concern for a myeloproliferative neoplasm (MPN), although MPNs are not known to be associated with SCD. However, within 24 hours, his WBC count decreased to 30.7 × 109/L, and his parvovirus polymerase chain reaction was reported as positive. Following transfusion with 10 mL/kg packed RBCs, his tachycardia and abdominal pain resolved, and no further interventions were employed. Within 1 week, his WBC count had normalized to 9.4 × 109/L.
Leukoerythroblastosis that mimics juvenile myelomonocytic leukemia has been reported in neonates with Epstein-Barr virus and cytomegalovirus infections. However, this case of extreme leukocytosis represents an unusual and rarely reported presentation of parvovirus infection in a splenectomized toddler.
For additional images, visit the ASH IMAGE BANK, a reference and teaching tool that is continually updated with new atlas and case study images. For more information visit http://imagebank.hematology.org.